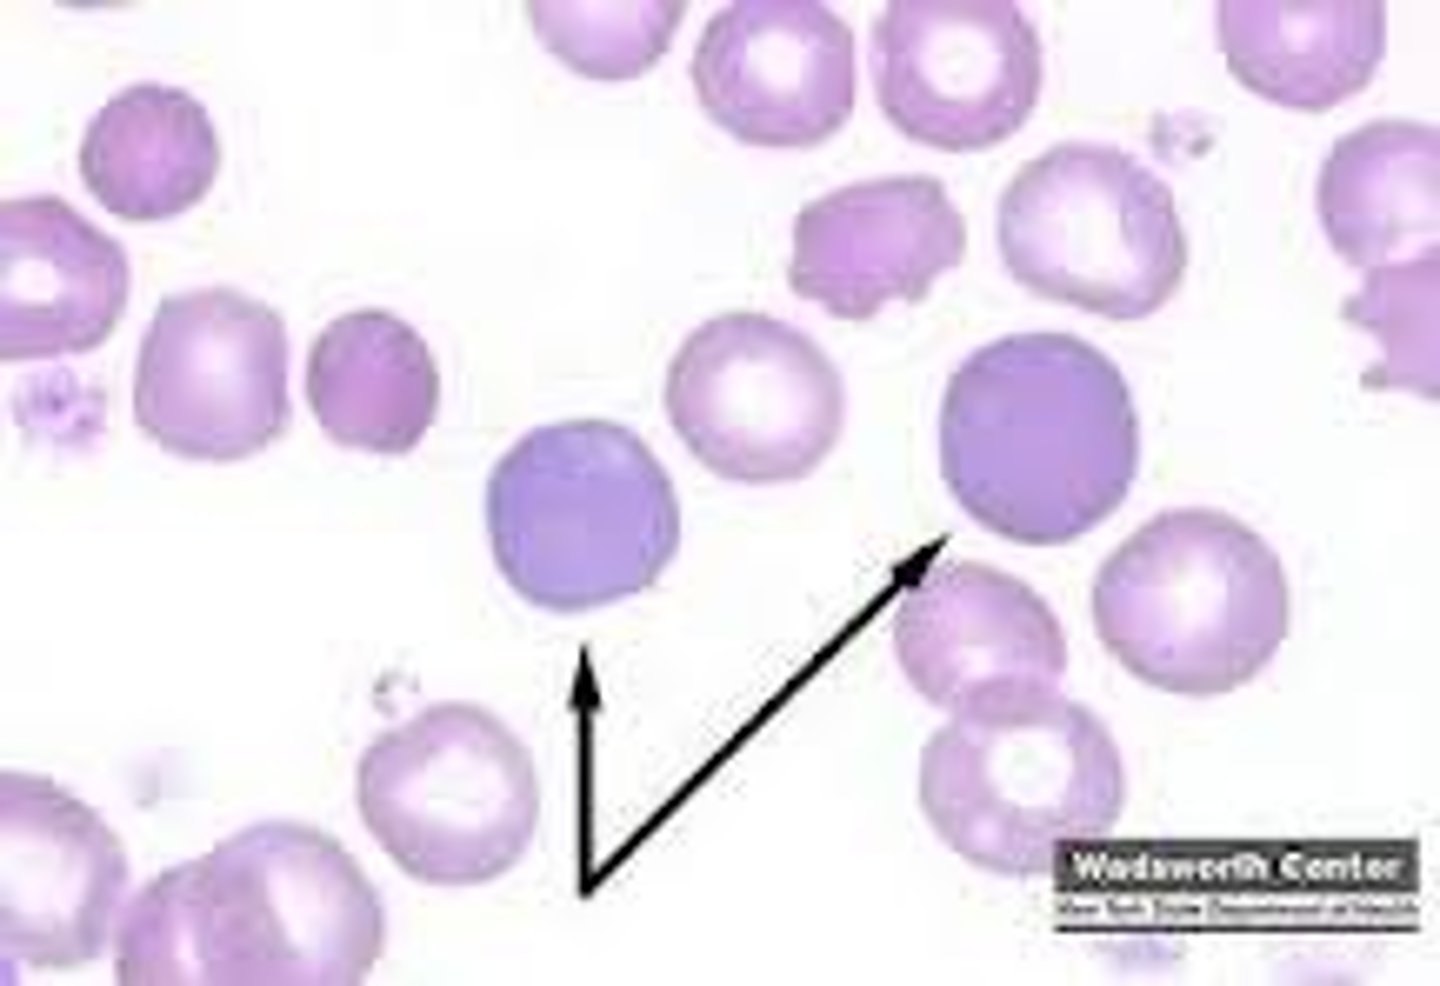
<p>polychromatophil</p>
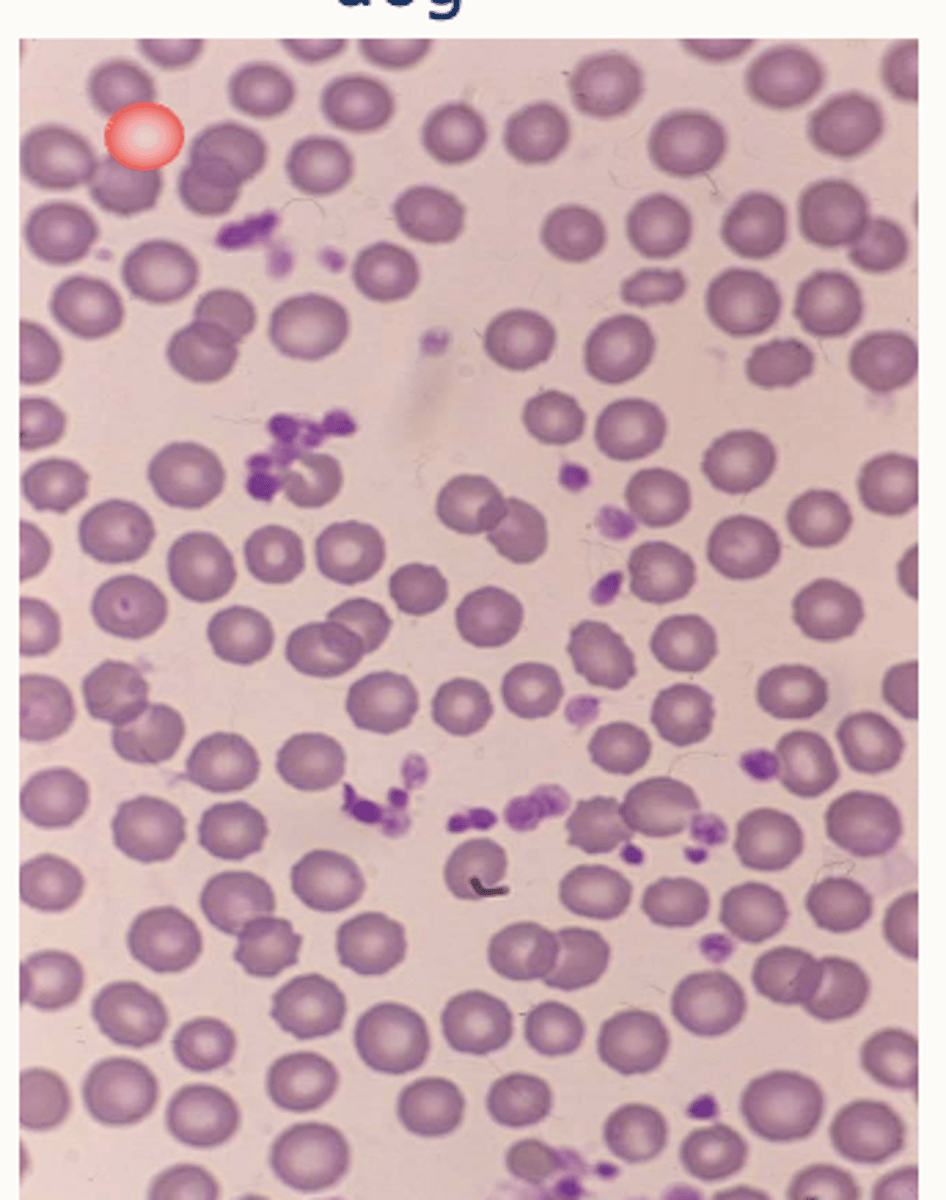
<p>Larger erythrocytes</p><p>Uniform size</p><p>Central pallor</p>
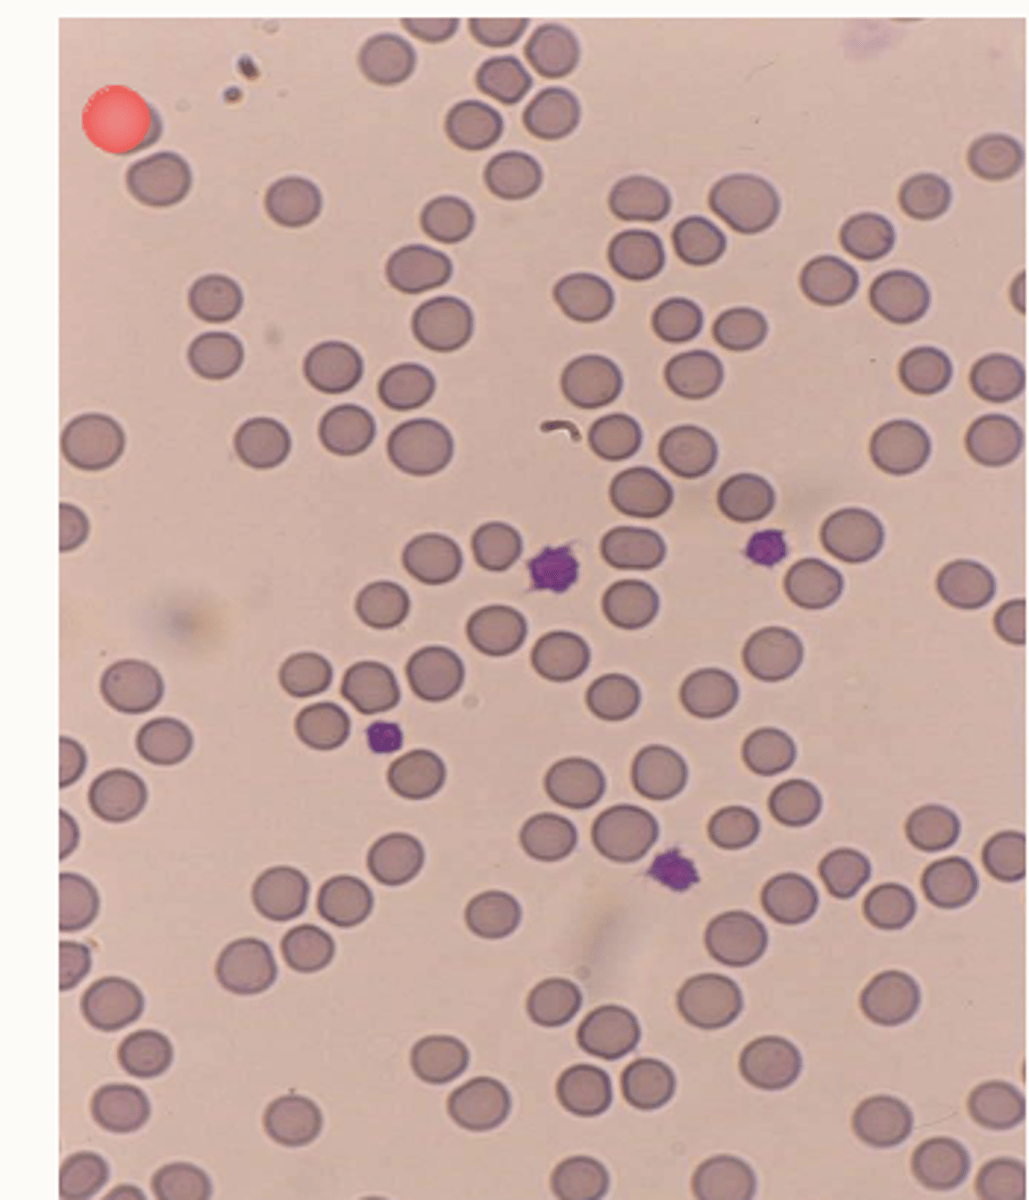
<p>Smaller erythrocytes</p><p>Mild anisocytosis (variation in size)</p><p>Scarce central pallor (less concave)</p>
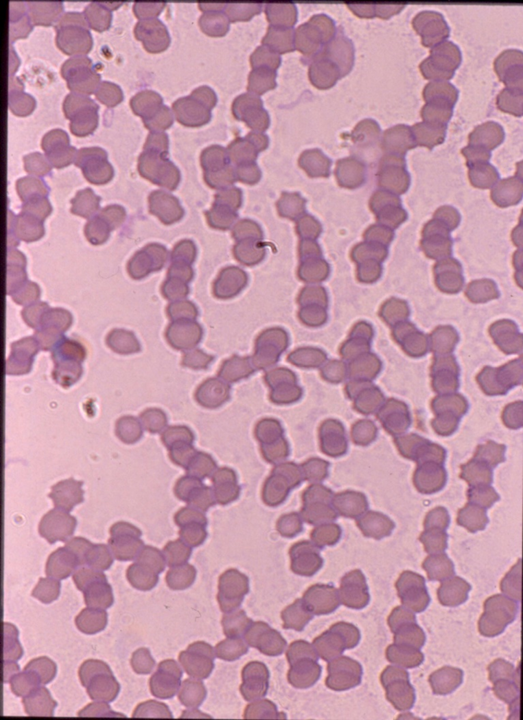
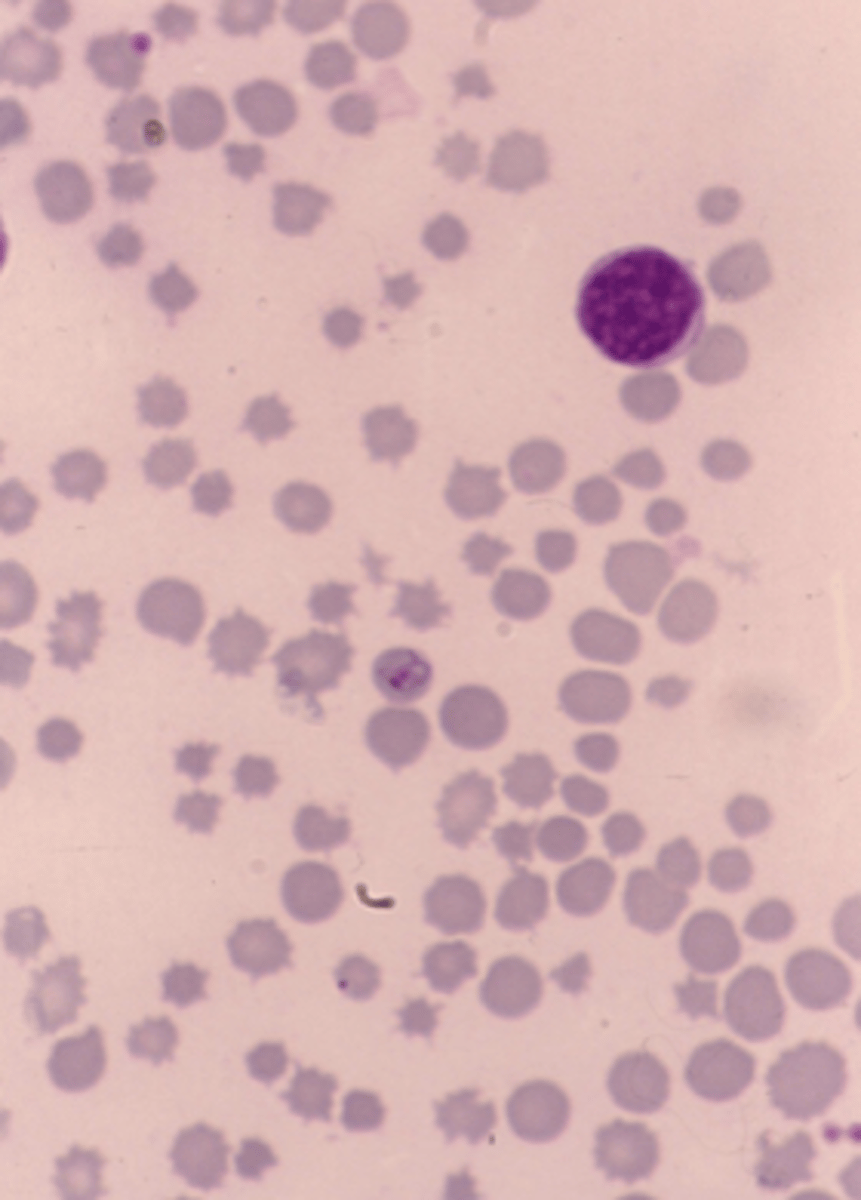
<p>Anisocytosis and crenation (spikes)</p>
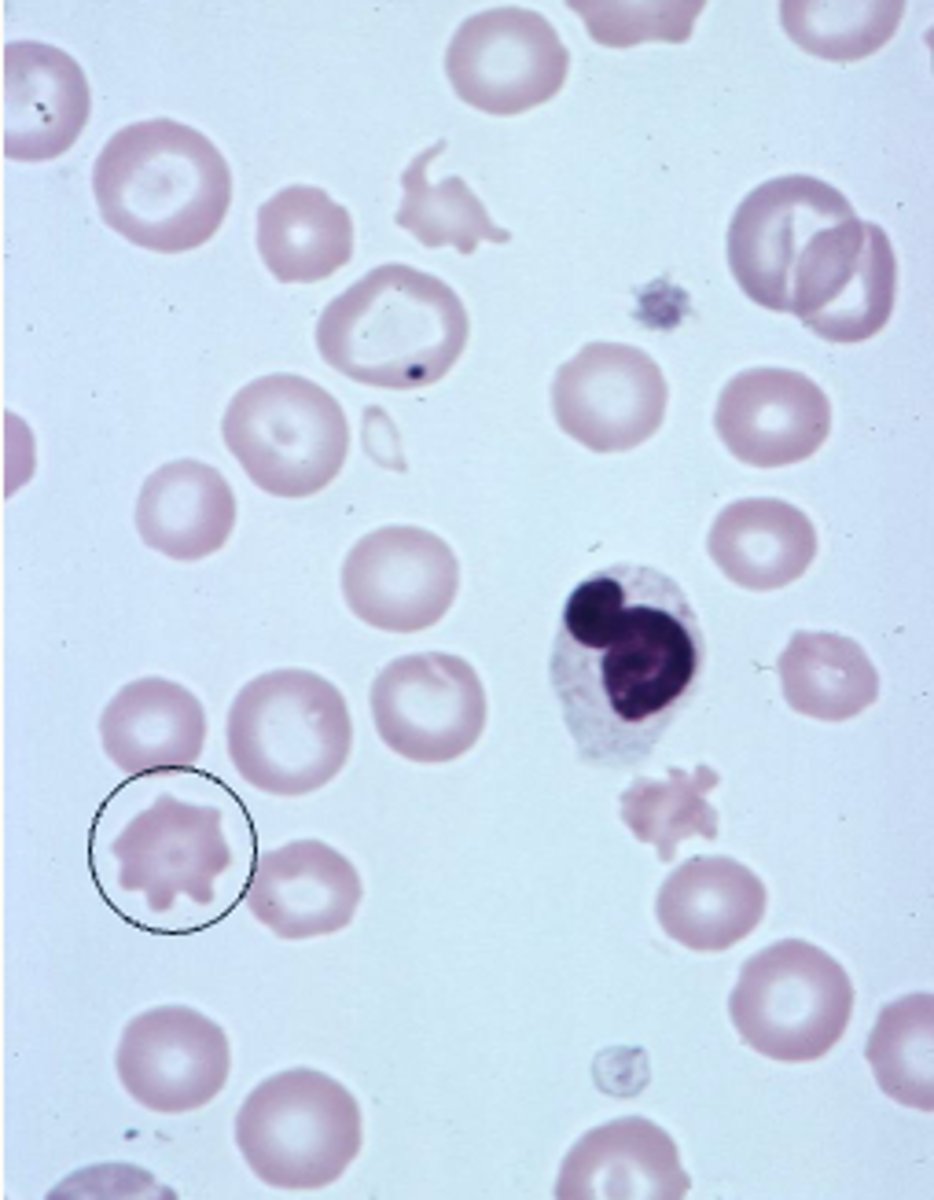
<p>describe the rbc</p>
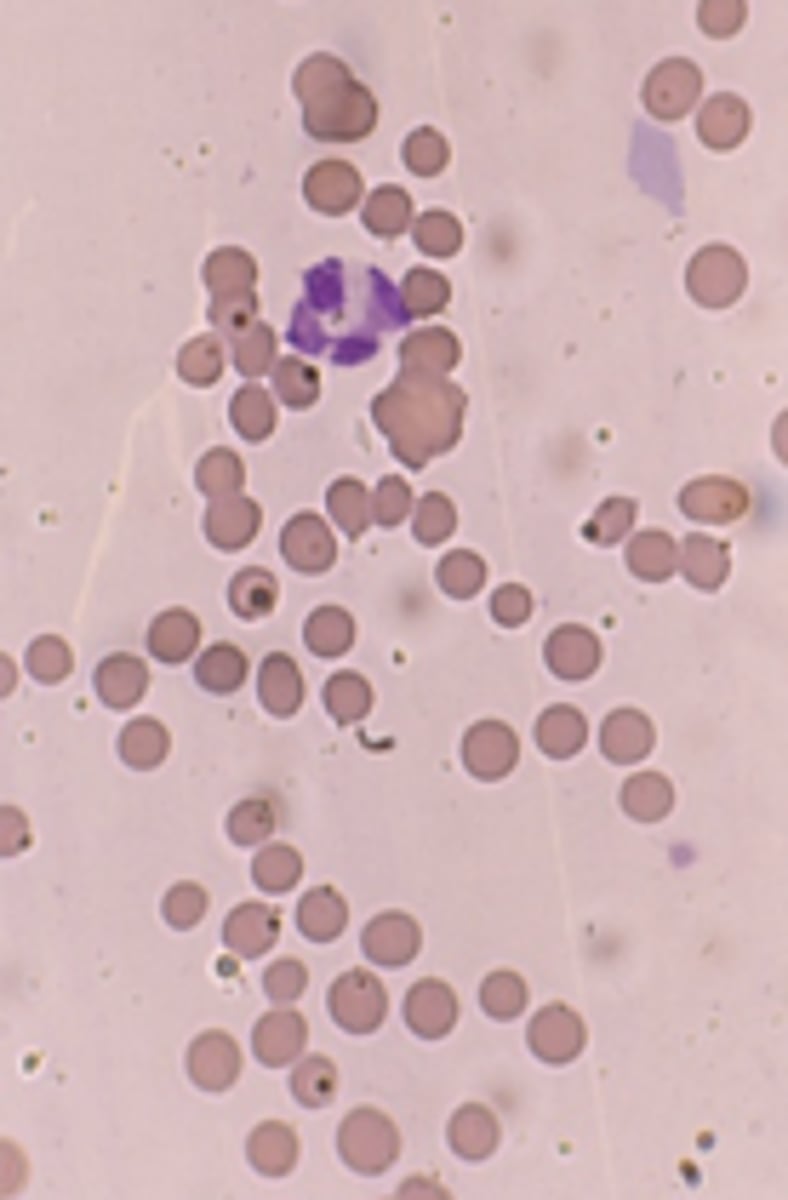
<p>§Immune-mediated haemolytic anaemia</p><p>§Mismatched blood transfusion</p>

1/76
Looks like no tags are added yet.
Name | Mastery | Learn | Test | Matching | Spaced | Call with Kai |
|---|
No analytics yet
Send a link to your students to track their progress
what are the three parts of a haemotology report
erythron, leukon, thrombon,

what are we evaluating in a red cell assessment
1. mass
2. evidence for effective and appropriate eryhtropoeisis
3. size and variation
4. haemoglobinisation
5. shapes and inclusions
how is red cell mass assessed
PCV/Hct (Packed Cell Volume / Hematocrit): proportion of blood occupied by RBCs
RBCC (Red Blood Cell Count)
Hemoglobin (Hgb)
how is evidence for effective and appropriate erythropoeisis assessed?
§size and colour (MCV, MCHC)
§reticulocyte count
how is red cell size and variation assessed?
MCV (Mean Corpuscular Volume): average size of RBCs
RDW (Red cell Distribution Width): variation in RBC size (anisocytosis)
how is red cell haemoglobinisation (colour) assessed?
MCHC (Mean Corpuscular Hemoglobin Concentration): average hemoglobin concentration in a red cell
Hypochromic → pale cells (iron deficiency)
Normochromic → normal color
how is red cell shape and inclusions assessed?
smear
questions to ask when evaluating the erythron
Is there inadequate, adequate or excessive red cell mass to deliver oxygen to tissues?
Is there evidence of anaemia?
Is there evidence of regeneration?
What is the cellular character of the anaemia?
Normocytic/macrocytic/microcytic; normochromic/hypochromic
Is there evidence of polycythaemia
Relative or absolute?
polycythemia
too many rbc
can be relative or absolute
what is relative polycythaemia?
a reduced plasma volume makes it appear as though there are more red blood cells (higher concentration) despite normal RBC levels
what is absolute polycythaemia?
True increase in RBC mass due to increased RBC production/release
what are PCV, RBCC and Hgb used to measure?
three are measures of red cell mass and oxygen carrying capacity
Usually interpret them as a block
what are pcv rbcc and hgb all equally effected by?
haemoconcentration
Will usually increase and decrease in line with one another
why would a PCV be wrong?
1. RBC's miscounted
Mistaken for platelets
Aggregated into pairs and triplets
2. MCV misleading
Cell shrinkage or swelling
Transport, tube filling
Osmotic effects in machine
how to calculate PCV
MCV x RBCC
why is a high MCHC misleading?
§Not physiologically possible to cram more Hgb into red cells than they will take
what are causes of a high MCHC
§Haemolysis (sample handling or intravascular)
§Lipaemia
why may a MCV reading be misleading?
§Swelling from transport
§Mis-identification - pairs and triplets, cross over with large platelets
§Cell shrinkage or expansion in sample e.g. hyperosmolar
§Will impact on calculated PCV/HCT
how can haemolysis of a blood sample occur
sample handled poorly or theres a problem
cells release the haemoglobin
how can lipaemic samples interfere with MCHC
will interfere with light transmission through the sample and so will interfere with how we measure Hb
how can a rule of three error be picked up?
by looking at MCHC
Hct should roughly equal 3 × Hgb. If it doesn't, check for errors in the sample, the machine, or unusual red cell size/color.
Hct (%) approx. = Hgb (g/dL) x 3 (+/- 3%).
What is the classification of anaemia based on?
MCV and MCHC
What is a limitation of using MCV and MCHC for anaemia classification?
They are blunt measures.
We may see changes with the microscope that may not be sufficient to push parameter out of reference range
What can be more sensitive than MCV and MCHC in detecting changes in anaemia?
Machine dot-plots and histograms.
What type of anaemia is often classified as normocytic normochromic?
Anaemia of illness or pre-regenerative or occasionally non-regenerative.
What type of anaemia is classified as macrocytic hypochromic?
Classic highly regenerative anaemia.
lots of young red cells coming in which are bigger but theyve got the right amt of Hb but bc its a bigger space the Hb is conc is less
What can sometimes cause macrocytic hypochromic anaemia aside from regeneration?
Cell swelling of transport.
What type of anaemia is classic for iron deficiency?
Microcytic hypochromic anaemia.
What condition can occur without anaemia related to microcytic hypochromic classification?
Portosystemic shunts.
what is polycythaemia
Increase in PCV, Hgb concentration and RBC count
What is relative polycythaemia?
PCV is increased but there is no increase in RBC production.
Apparent increase in RBC due to a decrease in fluid in circulation (often total protein and albumin)
theres just less fluid
common causes of relative polycythaemia?
1. Dehydration (loss of plasma/water)
Causes: Vomiting, diarrhoea, Polyuria, Extensive burns, Water deprivation or adipsia
Exercise, fear, excitement, severe pain - stress:
Adrenaline secretion, splenic contraction and transient redistribution of RBC from the spleen to the circulation
how does relative polycythaemia resolve?
§Resolves after rehydration or removal of cause of splenic contraction
what is absolute polycythaemia
True increase in RBC mass due to increased RBC production/release (usu polychromasia, anisocytosis and reticulocytes)
more rbcs produced
what does polycythaemia imply
increased number of several haemopoetic cell lines (human), however dogs & cats with polycythaemia vera usually have normal neutrophil & platelet counts!
what is primary polycythaemia? (polycytheamia vera)
rare myeloproliferative disorder
abnormal response of RBC precursors
Normal EPO levels
what is secondary polycythaemia?
Chronic tissue hypoxia of renal tissues (low arterial pO2) due to:
heart/lung diseases, high altitude, thrombosis, constriction of renal vessels
Renal tumor or cysts [↑intra-capsular pressure]
increased epo
how can the example of a kidney tumour cause secondary polycythaemia
kidney has tight capsule
turmour → pressure in capsule increases
less blood gets in there
sensors dont get the blood flow and o2 levels to think things are normal
so release epo to ‘correct’ this
polycythaemia
what are reticulocytes?
Young (immature/non-nucleated) erythrocytes prematurely released to blood from the bone marrow in regenerative anaemias.
how to visualise reticulocytes?
New methylene blue (NMB) precipitation demonstrates RNA-protein complexes (ribosmal RNA & mitochondria).
whats this

reticulocytes
stained with new methylene blue → shows rna protein complexes
young red cells including reticulocytes have a what kind of appareance on romanowsky routine stain?
polychromatophil
clinical applications of reticulocytes
Evaluation of erythropoiesis in bone marrow.
Differentiation of regenerative and non-regenerative anaemia.
how to conduct a reticulocyte count?
Manual
Automated (some haematological analysers)
how to calculate absolute reticulocyte count (ARC)?
observed % reticulocytes x RBC (x10^12/l) x 10
Why ARC is important
Independent of variation of RBC numbers
More accurate than just the % reticulocytes:
A patient with anemia may have a high % reticulocytes, but the absolute number may be normal if RBC count is low
whats the difference between the 2 types of reticulocytes in cats,
difference is to do with a different pattern of dots in the red cell.
aggregate: blue stained coarse clumping
punctate: small, blue stained dots
What is the typical reticulocyte response in dogs?
Low number of reticulocytes (<1%)
What reticulocyte count is expected in regenerative anaemias in dogs?
At least (>60x10^9/L)
What is the typical reticulocyte response in cats?
Low number of reticulocytes (0.2-1.6%)
What are the two morphological types of reticulocytes in cats?
'Aggregate' and 'punctate'
What is the percentage of 'aggregate' reticulocytes in cats?
0.5% of erythrocytes
What is the percentage of 'punctate' reticulocytes in cats?
1-10% of erythrocytes
Which type of reticulocyte is considered in the assessment of regeneration in cats?
'Aggregate' reticulocytes
What reticulocyte count is expected in regenerative anaemia in cats?
At least (>50x10^9/L)
What is the typical reticulocyte response in ruminants and horses?
Virtually no reticulocytes in normal blood
Can reticulocytes appear in severe anaemias in horses?
No, reticulocytes may not appear even in very severe anaemias
When does peak reticulocyte production occur in cattle after acute blood loss?
7-14 days post acute blood loss

what does this show
Of the species we commonly deal with, dogs have probably
got the biggest red cells, whereas goats have got really,
really tiny ones.
But because there needs to be a certain amount of
haemoglobin to transport the right amount of oxygen across all
of these species, what we can recognise is that animals
that have got smaller volumes
will generally have larger numbers, so they all end up
with quite a similar pack cell volume.
describe the blood morphology in a dog
Larger erythrocytes
Uniform size
Central pallor
describe the blood morphology in a cat
Smaller erythrocytes
Mild anisocytosis (variation in size)
Scarce central pallor (less concave)
describe the blood morphology in a horse
Rouleaux
(sedimentationtendency)
describe the blood morphology in a ruminant
Anisocytosis and crenation (spikes)
what are the Variations within dog breeds
Macrocytosis in some poodles
Akitas have unusually small erythrocytes & particularly high potassium content
Greyhounds have high PCVs (0.55-0.6 L/L)
what is poikilocytosis
abnormally shaped RBCs

what can alterations in red cell shape indicate?
abnormal erythropoeisis
specific organ dysfunction
examples of common abnormal rbc shapes
Codocytes (Target cells, Fe defic)
Spherocytes (IMHA)
Acanthocytes → irregularly spiked cells
Schistocytes→ broken cells
Echinocytes (Artefacts) crenation - 'burr cells' → regularly spiked cells
what are red cell inclusions?
abnormal material inside RBCs
what are examples of inclusions?
Howell Jolly bodies → nuclear remnants
Basophilic stippling → in cytoplasm
Nucleated RBC's
Infectious agents
Mycoplasma
Babesia
Viral inclusions
Heinz bodies

describe the rbc
schistocytes
RBC fragments
describe the rbc
acanthocytes
irregular elongations of rbc border with sounded ends

describe the rbc
crenation/ echinocytes
numerous pin point projections, even and regular
what are the types of red blood cell distribution
§Rouleaux formation
agglunination
explain the roleaux formation
§Clustering, sticky, piling of RBCs (look like stacks of coins)
§Normal finding in horses

what does the roleaux formation occur?
Relates to increased "stickiness" of plasma with increased globulin content
indicates inflam in SA
When does agglutination occur?
§Immune-mediated haemolytic anaemia
§Mismatched blood transfusion
how do you confirm if its agglutination
saline agglutination test:
Mix 1 drop of blood with 1 drop of saline
Æ Agglutination will persist, rouleaux formation will disperse
